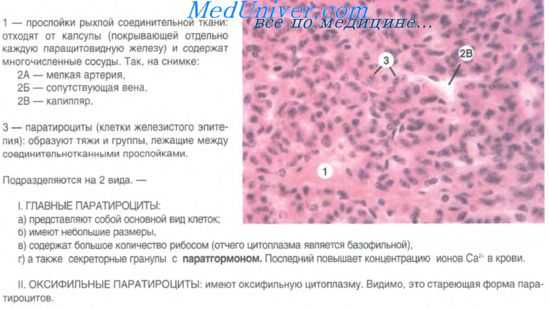
околощитовидные железы

Околощитовидные железы. Паратирин. Паратгормон. Кальцитриол. Регуляторные функции гормона околощитовидных желез.
Добавил пользователь Евгений Кузнецов Обновлено: 30.10.2025
Паратиреоидный гормон (ПТГ) – полипептидный гормон, который синтезируется паращитовидными железами и играет важную роль в регуляции уровня кальция и фосфора в организме.
Синонимы русские
Паратгормон, паратирин, ПТГ.
Синонимы английские
Parathyroid hormone, intact PTH, parathormone, parathyrin.
Метод исследования
Твердофазный хемилюминесцентный иммуноферментный анализ ("сэндвич"-метод).
Диапазон определения: 1,2 - 5000 пг/мл.
Единицы измерения
Пг/мл (пикограмм на миллилитр).
Какой биоматериал можно использовать для исследования?
Как правильно подготовиться к исследованию?
- В течение суток до исследования не употреблять алкоголь, а также лекарственные препараты (по согласованию с врачом).
- Не есть 12 часов перед анализом.
- Исключить физическое и эмоциональное перенапряжение в течение 24 часов до исследования.
- Не курить 3 часа до исследования.
Общая информация об исследовании
Паратиреоидный гормон (ПТГ) вырабатывается паращитовидными железами, расположенными попарно на задней поверхности каждой из долей щитовидной железы. Интактный ПТГ (цельная молекула гормона) состоит из 84 аминокислот, имеет короткий период полужизни (около четырех минут) и является главной биологически активной формой гормона. У его N- и C-терминальных фрагментов период существования более длительный, их активность и метаболизм изучаются.
ПТГ играет важную роль в регуляции фосфорно-кальциевого обмена и обеспечивает поддержание стабильной концентрации кальция и фосфора во внеклеточной жидкости. Уровень ПТГ тесно связан с количеством кальция, витамина D, фосфора, кальция, магния в организме, регуляция его секреции осуществляется по принципу обратной связи. При снижении концентрации кальция в крови (гипокальциемии) выделение ПТГ паращитовидными железами усиливается, а при повышении (гиперкальциемии) – наоборот, снижается. Данные механизмы направлены на поддержание стабильного уровня кальция в крови. Повышение ПТГ способствует активации остеокластов, резорбции костной ткани и высвобождению кальция из костей, усиливает всасывание кальция из кишечника, задерживает выделение кальция почками и ингибирует обратную реабсорбцию фосфора. Антагонистом ПТГ является гормон кальцитонин, секретируемый С-клетками щитовидной железы. В норме при достижении нормальной концентрации кальция в крови продукция ПТГ снижается.
При патологии и избыточном синтезе ПТГ (гиперпаратиреозе) развивается гиперкальциемия, гиперфосфатурия, генерализованный остеопороз, кальцификация сосудов, поражение слизистой желудочно-кишечного тракта. Недостаточная секреция ПТГ (гипопаратиреоз) сопровождается гипокальциемией и гиперфосфатемией, может привести к судорогам, тетании.
Важно одновременно оценивать уровень свободного, или ионизированного, кальция в крови и ПТГ с учетом клинических проявлений и результатов других лабораторных и инструментальных исследований, это позволяет провести дифференциальную диагностику очень схожих патологических состояний и разработать правильную тактику лечения.
Для чего используется исследование?
- Для оценки функции паращитовидных желез.
- Чтобы выяснить причины гипо- или гиперкальциемии, нарушений кальциевого обмена.
- Для дифференциальной диагностики первичного, вторичного и третичного гиперпаратиреоза.
- Для диагностики гипопаратиреоза.
- Для мониторинга пациентов с хроническим нарушением обмена кальция.
- Чтобы оценить эффективность лечения патологии паращитовидных желез и их оперативного удаления при новообразованиях.
Когда назначается исследование?
- При изменении уровня кальция в крови (гипер- или гипокальциемии).
- При симптомах гиперкальциемии (усталость, тошнота, боли в животе, жажда) или гипокальциемии (боли в животе, мышечные судороги, покалывание в пальцах).
- При изменении размеров и структуры паращитовидных желез по данным инструментальных методов (например, КТ).
- При лечении нарушений кальциевого обмена.
- При новообразованиях паращитовидных желез, а также сразу после их хирургического удаления.
- При остеопорозе и изменениях структуры костной ткани.
- При хронических заболеваниях почек и сниженной скорости клубочковой фильтрации.
Что означают результаты?
Референсные значения: 15 - 65 пг/мл.
Нормальный уровень ПТГ при низком кальции в крови – признак гипопаратиреоза (недостаточного синтеза ПТГ паращитовидными железами). Высокий ПТГ и повышенная концентрация кальция в крови указывают на гиперпаратиреоз. Уровень ПТГ оценивается совместно с уровнем кальция крови.
Околощитовидные железы. Паратирин. Паратгормон. Кальцитриол. Регуляторные функции гормона околощитовидных желез.
Околощитовидные железы. Развитие околощитовидных желез. Строение околощитовидных желез. Гормоны околощитовидных желез.
Функция околощитовидных желез состоит в выработке полипептидного гормона — паратирина (паратгормона), который участвует в регуляции обмена кальция и фосфора в организме. Паратирин повышает содержание кальция в крови. Гиперкальциемический эффект паратирина обусловлен активацией остеокластов и подавлением остеоцитов, что приводит к резорбции кости и выходу кальция в кровь, усилению всасывания кальция в кишечнике и ускорению реабсорбции кальция в почках. Кроме паратирина на содержание кальция в организме влияет кальцитонин щитовидной железы.
Взаимодействие этих гормонов с противоположным действием обеспечивает кальциевый и фосфорный гомеостаз в организме.
Развитие околощитовидных желез.
Они называются главными паратироцитами. У 5-месячного плода главные паратироциты дифференцируются на светлые и темные паратироциты. На десятом году жизни появляется следующий вид эпителиальных клеток желез — ацидофильные, или оксифильные, паратироциты. В виде единичных включений в паренхиме околощитовидных желез могут находиться С-клетки, вырабатывающие кальцитонин.
Строение околощитовидных желез.
Паренхима железы образована эпителиальными трабекулами, клеточными тяжами и реже — комплексами в виде фолликулов с оксифильным содержимым. Нежные прослойки соединительной ткани, содержащие густые сети кровеносных капилляров, делят железу на мелкие дольки. Ведущим клеточным диффероном среди железистых клеток составляют главные паратироциты. Это клетки полигональной формы, в светлой цитоплазме которых определяются включения гликогена и ли-пидов. Размеры клеток колеблются от 4 до 10 мкм.
Среди главных паратироцитов различают активные (темные) и неактивные (светлые) формы. В активных клетках сильнее развиты органеллы, в неактивных — больше липидных капель и гликогена. По соотношению двух видов паратироцитов можно судить о функциональной активности железы. Обычно на один темный приходится 3-5 светлых паратироцитов.
Среди главных паратироцитов в паренхиме околощитовидной железы встречаются скопления оксифильных (ацидофильных) паратироцитов. Эти клетки крупнее главных, в цитоплазме их содержится большое количество оксифильных зерен. Последние при электронной микроскопии являются митохондриями, которые занимают большую часть цитоплазмы. При этом секреторные гранулы не выявляются. Предполагают, что ацидофильные паратироциты — это стареющие, дегенеративно измененные формы главных паратироцитов.
В железах у лиц пожилого возраста обнаруживаются фолликулы с коллоидоподобным содержимым. Гормон в фолликуле не обнаружен.
Секреторные гранулы выводятся из клетки экзоцитозом. Уменьшение концентрации кальция и фосфора приводит к активации синтеза паратгормона. Рецепторно-трансдукторная система клетки воспринимает уровень внеклеточного кальция, и происходит активация секреторного цикла клетки и секреция гормона в кровь.
Реактивность. Разрастание эпителия околощитовидной железы, приводящее к ее гиперфункции, вызывает нарушение процесса обызвествления костной ткани (остеопороз, остеомаляция) и выведение кальция и фосфора из костей в кровь. При этом происходят резорбция костной ткани, нарастание количества остеокластов, разрастание фиброзной ткани. Кости становятся хрупкими, что приводит к повторным их переломам.
Гипофункция околощитовидной железы (травмы, удаление во время операции, инфекции) вызывает повышение нервно-мышечной возбудимости, ухудшение сократительной способности миокарда, судороги в связи с недостатком кальция в крови.
Регуляция обмена витамина D, паратгормона и костной ткани
Физиология паратгормона настолько сильно связана с витамином D и метаболизмом костной ткани, что рассматривать эти вопросы по отдельности, не потеряв их сути, невозможно. Графически взаимоотношения представлена на рисунке ниже. Паратгормон в первую очередь регулирует содержание ионов кальция в межклеточном пространстве. Витамин D контролирует всасывание кальция из пищи, а также косвенно отвечает за минерализацию костной ткани, которая содержит в себе 99% всего кальция организма.
«Можно ли считать кость органом?» Да! Поскольку костная ткань проявляется очень высокую метаболическую активность, а также содержит большие запасы кальция, она напрямую включена в процессы регуляции содержания кальция в межклеточном пространстве и плазме крови. Нормальная концентрация кальция в межклеточном пространстве необходима для выполнения множества клеточных функций, среди которых передача сигнала между клетками, секреция гормонов, нормальная работа мышц и нервов, поэтому необходимо строгое ее сохранение в определенных пределах.
Гипокальциемия ведет к нервно-мышечной гипервозбудимости; умеренное снижение уровня кальция проявляется гиперестезиями с положительными симптомами Хвостека и Труссо; тяжелая гипокальциемия ведет к развитию тетании, судорог и смерти. Гиперкальциемия проявляется летаргией, слабостью, комой и, наконец, смертью. Около 50% внеклеточного кальция находится в ионизированной форме, но точное соотношение зависит от pH. Содержание кальция внутри клеток на порядки меньше, чем вне ее, но некоторые органеллы, например, митохондрии, содержат в себе повышенные концентрации кальция. Колебания уровня внеклеточного ионизированного кальция обычно не превышают ± 10%.
а) Физиология обмена паратгормона. Паратгормон (паратиреоидный гормон, ПТГ, РТН) по химическому строению является 84-аминокислотным полипептидом; было выяснено, что за биологическую активность гормона ответственны первые 34 аминокислотных остатка паратгормона, именно они используются в клинической практике, например, в лечении остеопороза. Определение последовательности классического рецептора ПТГ показало его связь с G-белком и наличие семи трансмембранных сегментов, проявляющих одинаковое сродство как с паратгормоном, так и с ПТГ-родственным пептидом (ПТГ-рП).
Но ПТГ-рП не обладает таким же активирующим действием на 1-гидроксилазы почек, как сам ПТГ.
Наибольшее количество рецепторов к ПТГ находится в костной ткани и в почках, хотя в других органах они также присутствуют в меньших количествах. Недавно был обнаружен новый подвид ПТГ-рецептора, который связывается с карбоксильным остатком паратгормона. Ранее считалось, что данные рецепторы находятся в неактивном состоянии. Этот недавно обнаруженный рецептор не связывается с ПТГ-рП. Неизвестно, играет ли он какую-либо роль в метаболизме костной ткани или имеет какие-либо другие функции.
Клетки паращитовидных желез также экспрессируют рецепторы, чувствительные к кальцию. И они являются рецепторами, связанными с G-белками, и имеют в своем составе семь трансмембранных доменов. Данные рецепторы могут соединяться с различными катионами, но физиологически подходящими для них являются только двухвалентные катионы кальция и магния. Снижение уровня ионизированного кальция ведет к повышению секреции ПТГ, повышение уровня ионизированного кальция ведет к снижению секреции ПТГ.
Таким образом, и концентрация ионизированного кальция, и концентрация ПТГ в плазме крови колеблются лишь в узких пределах. Были описаны различные мутации данных рецепторов, некоторые из них приводят к повышению их активности, другие — к понижению. Данные мутации являются ключом к пониманию семейной гипокальциурической гиперкальциемии и некоторых гипокальциемических синдромов, например, семейного гипопаратиреоидизма.
Паратгормон (ПТГ) повышает резорбцию кальция в почках, усиливает резорбцию костной ткани, повышает активность D1-гидроксилазы почек. Эти механизмы помогают восстановить уровень кальция в плазме крови.

Пути метаболизма витамина D, паратгормона и костной ткани.
Предшественники витамина D синтезируются в коже под действием ультрафиолета. Превращение 25-ОН витамина D, депонированной формы витамина, в активную форму,
т.е. 1,25-(ОН)2 витамин D, регулируется паратгормоном. 1,25-(ОН)2 витамин D повышает всасывание кальция в желудочно-кишечном тракте.
Кальций и фосфор плазмы крови регулируют содержание паратгормона крови, а также участвуют в минерализации новообразованного костного матрикса.
При повышении уровня паратгормона усиливается резорбция костной ткани, поскольку это необходимо для поддержания необходимого уровня кальция в плазме,
а также стимулируется синтез 1,25-(ОН)2 витамина D почками.
б) Физиология обмена витамина Д. Синтез провитамина D (холекальциферола) происходит в коже из 7-дегидрохолестерола в результате фотокатализа под действием ультрафиолетовых лучей с длиной волны 290-315 нм. Ультрафиолетовые лучи именно с такой длиной волны могут преодолеть атмосферу, поэтому у жителей возвышенностей синтез провитамина D подвержен сезонным колебаниям. Синтез предшественников провитамина D тоже зависит от воздействия солнечных лучей, поэтому избыточное пребывание на солнце не приводит к гипервитаминозу.
Следовательно, скорость продукции провитамина D в долгосрочной перспективе не зависит от пигментации кожи; но она может снижаться у темнокожих лиц, которые мало подвергаются воздействию солнечных лучей. Провитамин D связывается с транскальциферином (витамин - D - связывающим белком) и транспортируется в печень, где в результате 25-гидроксилирования он превращается в кальцидиол.
Возможности получения витамина D с пищей очень ограничены, лишь крайне малое число продуктов содержит в себе витамин D. Молоко и молочные продукты, производимые в США и Европе, дополнительно обогащаются витамином D. Одна их порция содержит около 100 ME витамина. К сожалению, необогащенные молочные продукты и человеческое грудное молоко содержат крайне малое количество витамина. В желтке яйца содержится около 20 ME витамина D, в белке витамина D нет. Рыба является источником, богатым витамином D.
В порции консервированного тунца содержится 250 ME витамина, а в одной порции свежевыловленного лосося может содержаться до 1000 ME. В растительных продуктах витамина D нет, но он может содержаться в грибах в количестве до 1500 МЕ/100 г, если грибы росли в присутствии солнечного света.
Витамин D представляет из себя провитамин, активной формой которого является 1-25-(ОН)2 витамин D (кальцитриол). В норме кальцитриол продуцируется почками из витамина D, кальцидиола, в результате реакции 1-гидроксилирования. Активность 1-гидроксилазы почек контролируется ПТГ, поэтому уровень 1-25-(ОН)2 витамина D напрямую коррелирует с уровнем ПТГ. Высокий уровень ПТГ, как правило при гипокальциемии, стимулирует образование 1-25-(ОН)2 витамина D. В результате происходит повышение абсорбции кальция в кишечнике и нормализация его уровня в плазме крови.
При определенных патологических состояниях некоторые другие ткани также могут проявлять 1-гидроксилазную активность, иногда независимо от действия ПТГ.

в) Метаболизм минеральных веществ в костной ткани. Мы часто воспринимаем кости лишь как опорные структуры, но на самом деле костная ткань играет важную роль в метаболизме, выступая в качестве депо кальция, фосфатов и карбонатов, также она участвует в поддержании кислотно-щелочного равновесия. Матриксом кости является частично минерализованная ткань и специфические костные клетки. Костную систему человека разделяют на осевой скелет, к которому относят череп, позвоночный столб, грудину, ребра и таз, и на скелет конечностей, от их проксимальных отделов до кончиков пальцев.
Также костная ткань подразделяется на губчатую (трабекулярную), которая обладает высокой метаболической активностью, и кортикальную, которая имеет большую плотность и меньшую метаболическую активность. Изменения в кортикальной костной ткани наступают при тяжелых или длительно текущих заболеваниях. В осевом скелете преобладает содержание трабекулярной кости, в скелете конечностей — кортикальной.
К костным клеткам относят остеобласты, остеокласты и остеоциты. Остеобласты происходит из мезенхимальных стволовых клеток, они образуют соединительнотканный матрикс кости, который затем минерализуется, формируя новую костную ткань. Большинство остеобластов подвергаются апоптозу, но часть из них остается включенной в костный матрикс и превращается в остеоциты, а другая часть остается на поверхности кости, формируя надкостницу.
Трансформируясь в остеоциты, эти клетки образуют длинные отростки, которыми они создают щелевой контакт с соседними клетками и с клетками надкостницы. Остеоциты воспринимают механическое давление, оказываемое на кость, и играют важную роль в моделировании костной ткани. Остеокласты представляют собой крупные многоядерные клетки, происходящие из одноядерных макрофагов. Процесс дифференцировки клеток в остеокласты происходит под контролем ядер-ного фактора кВ (каппа-Б, RANKL), продуцирующего в ходе апоптоза остеобластов, и под контролем колониестимулирующего фактора макрофагов.
Остеокласты участвуют в резорбции костной ткани, разрушая минеральный компонент и коллагеновый матрикс костной ткани посредством протеолиза.
В норме костная ткань постоянно разрушается остеокластами и одновременно заново синтезируется остеобластами. Этот процесс получил название ремоделирования костной ткани. В здоровом организме процессы разрушения и синтеза костной ткани находятся в равновесии. Ремоделирование костной ткани крайне важно для поддержания структурной целостности (прочности) скелета, т. к. с ее помощью постоянно восстанавливаются микропереломы костей, возникающие от каждодневных физических нагрузок.
г) Кальций-чувствительные рецепторы. Как уже упоминалось выше, паращитовидные клетки экспрессируют кальций-чувствительные рецепторы. Первоначально данные рецепторы были выделены из паращитовидных клеток крупного рогатого скота, затем их наличие было подтверждено и у человека. Кроме паращитовидных желез, где они и были впервые обнаружены, данные рецепторы экспрессируются в почках, костях, желудке, легких, головном мозге и других тканях.
Как мутации, так и приобретенные дисфункции данных рецепторов могут стать причиной появления различных заболеваний, связанных как с повышением, так и с понижением кальция крови. Более подробно эти заболевания будут рассмотрены ниже.
Учебное видео расшифровки биохимического анализа крови
Редактор: Искандер Милевски. Дата обновления публикации: 18.3.2021
Околощитовидные железы (у человека в среднем 4 железы) эпителиального происхождения, кровоснабжаются из щитовидных артерий и, так же как щитовидная железа, иннервируются симпатическими и парасимпатическими волокнами. Гормон околощитовидных желез — паратирин — является кальцийрегулирующим гормоном, повышающим уровень кальция в плазме крови, в связи с чем его называют гиперкальциемическим гормоном. Регуляция секреции паратирина происходит по механизму отрицательной обратной связи уровнем ионизированного кальция плазмы крови. Низкая концентрация кальция стимулирует секрецию паратирина при одновременном повышении уровня цАМФ в клетках. Стимулируют продукцию паратирина и симпатические влияния на клетки околощитовидных желез через бета-адренорецепторы, также приводящие к возрастанию в клетках железы содержания цАМФ. Подавляют секрецию паратирина высокий уровень кальция в крови и почечный гормон кальцитриол.

Рис. 6.19. Регуляция секреции и основные эффекты паратирина. Снижение уровня кальция в крови является стимулом для околощитовидных желез (ОЩЖ), секретирующих паратирин. Основные эффекты паратирина проявляются со стороны органов-мишеней: почек (подавление реабсорбции кальция и его выведение с мочой, повышение реаб-сорбции фосфата), кишечника (стимуляция всасывания кальция, в основном через стимуляцию синтеза в почках кальцитриола) и костной ткани (вымывание кальция в кровь). Эти эффекты ведут к повышению в крови уровня кальция (паратирин является гиперкальциемиче-ским гормоном).
Основные эффекты паратирина проявляются со стороны органов - мишеней гормона — костной ткани, почек и желудочно-кишечного тракта (рис. 6.19). Реализация действия паратирина осуществляется через цАМФ, и повышение уровня этого вторичного посредника в моче является важным диагностическим критерием избыточной секреции паратирина. Эффект гормона на костную ткань обусловлен стимуляцией активности и увеличением количества остеокластов, резорбирующих кость. Под влиянием паратирина в костной ткани накапливаются лимонная и молочная кислоты, вызывающие местный ацидоз. Кислая реакция среды в костной ткани тормозит активность щелочной фосфатазы — фермента, необходимого для образования основного минерального вещества кости — фосфорнокислого кальция. Избыток лимонной и молочной кислот ведет к образованию растворимых в воде солей кальция — цитрата и лактата, вымыванию их в кровь, что приводит к деминерализации кости. Избыток цитрата выводится с мочой, что является важным диагностическим признаком повышенного уровня секреции паратирина. В почках гормон снижает реабсорбцию кальция в проксимальных канальцах, но резко усиливает ее в дис-тальных канальцах, что предотвращает потери кальция с мочой и способствует гиперкальциемии. Реабсорбция фосфата в почках под влиянием паратирина угнетается, это приводит к фосфатурии и снижению содержания фосфата в крови — гипофосфатемии. Почечные эффекты паратирина проявляются также в диуретическом и натрийуретическом действии, угнетении канальцевой реабсорбции воды, снижении эффективности действия на канальцы вазопрессина. В кишечнике паратирин прямо, но главным образом опосредованно через кальцитриол, стимулирует всасывание кальция, что также способствует гиперкальциемии.
Паратирин повышает поступление кальция во внутриклеточную среду и транспорт иона из цитозоля во внутриклеточные депо, увеличивает удаление свободного кальция из клеток. Благодаря этому изменяется возбудимость и реактивность клеток к нейрогенным и гуморальным регуляторным стимулам. Паратирин вызывает повышение образования в почках кальцитриола, стимулирует секрецию соляной кислоты и пепсина в желудке.
Повышенная секреция паратирина при гиперплазии или аденоме околощитовидных желез сопровождается деминерализацией скелета с деформацией длинных трубчатых костей, образованием почечных камней, мышечной слабостью, депрессией, нарушениями памяти и концентрации внимания.
Информация на сайте подлежит консультации лечащим врачом и не заменяет очной консультации с ним.
См. подробнее в пользовательском соглашении.
Паращитовидные железы
Паращитовидные железы – железы внутренней секреции, расположенные на задней стенке капсулы щитовидной железы. Более правильным названием является термин «околощитовидные железы».
Расположение и количество паращитовидных желез
Размер паращитовидных желез – около 4х5х5 мм. В норме у человека может быть от 2 до 8 желез (типичное количество – 4, по две с каждой стороны – одна у верхнего полюса доли щитовидной железы, вторая – у нижнего полюса). Характерной и очень важной особенностью паращитовидных желез является изменчивость их расположения и количества. Существует значительное число возможных мест расположения желез – они могут находится и в вилочковой железе, и рядом с основным сосудисто-нервным пучком шеи, и за пищеводом, на передней поверхности позвоночника. Исключительная вариабельность расположения является важной особенностью, которую обязаны учитывать хирурги при проведении операций.
Функция паращитовидных желез
Основной функцией паращитовидных желез является выработка паратгормона – основного гормона, регулирующего уровень кальция в крови человека. Паратгормон представляет собой полипептидный (т.е. состоящий из аминокислот, в количестве 84 аминокислотных остатков) гормон. На поверхности клеток паращитовидной железы находятся рецепторы, которые способны определять концентрацию кальция в сыворотке крови. При снижении концентрации кальция паращитовидные железы начинают вырабатывать повышенные количества паратгормона, который оказывает три основных эффекта в организме. Первый эффект – снижение выделения кальция с мочой. Второй эффект – усиление гидроксилирования витамина D в почках и, как следствие, повышение концетрации активной формы витамина D (кальцитриола) в крови, который повышает выработку в стенке кишечника кальмодулина – транспортного белка, обеспечивающего всасывание кальция в кровь. Третий эффект – активация разрушающих кость клеток, остеокластов, с разрушением костной ткани и выделением содержащегося в ней кальция в кровь. Все три эффекта (уменьшение выделения кальция, усиление всасывания кальция, перевод костного кальция в плазму крови) направлены на повышение концентрации кальция в крови. Паратгормон является главным веществом, обеспечивающим нормальную концентрацию кальция в крови. Его антагонист – кальцитонин, вырабатываемый С-клетками щитовидной железы и некоторыми клетками кишечника, является достаточно слабым, поэтому значимого участия в регуляции фосфорно-кальциевого обмена не принимает.
Значение паращитовидных желез
Такой маленький орган, как паращитовидная железа, крайне важен для человеческого организма. Удаление паращитовидных желез приводит к резкому снижению концентрации ионизированного кальция в крови с последующим развитием судорог, приводящих к смерти. В XIX веке французская медицинская академия даже запретила проведение операций на щитовидной железе, поскольку все они заканчивались гибелью пациентов – дело в том, что в то время значение паращитовидных желез еще не было установлено, и хирурги всегда удаляли их при операции, что заканчивалось фатально. Только после открытия этих желез, описания особенностей их анатомического расположения и выяснения их функции стало понятно, насколько они важны. В настоящее время хирургия щитовидной железы ставит одной из важнейших задач обязательное сохранение паращитовидных желез и их кровоснабжения – именно эта задача является одной из наиболее сложных для хирурга-эндокринолога.
Как недостаточная (гипопаратиреоз), так и избыточная функция паращитовидных желез (гиперпаратиреоз) вредны для пациента. При гиперпаратиреозе, который чаще всего развивается вследствие образования доброкачественной опухоли паращитовидной железы (аденомы), паратгормон поступает в кровь бесконтрольно, в больших количествах. Вследствие избытка паратгормона происходит усиление работы остеокластов в костях, которое приводит к разрушению костей со снижением их прочности (остеопороз). Вследствие разрушения костной ткани и поступления в кровь больших количеств кальция возникает ряд осложнений – переломы даже при незначительной нагрузке, образование камней в почках, кальцификация сосудов и клапанов сердца, образование язв в желудке и двенадцатиперстной кишке и т.д. В тяжелых случаях уровень кальция достигает таких высоких значений, что приводит к ухудшению интеллекта вплоть до развития комы.
История открытия паращитовидных желез
Впервые паращитовидная железа была обнаружена при проведении вскрытия индийского носорога, который умер в зоопарке Лондона в 1850 г. Анатомировать носорога было поручено молодому исследователю Ричарду Оуэну, который после многомесячных исследований сумел обнаружить в туше животного паращитовидную железу весом 8 г. Это был первый случай выявления паращитовидной железы. С тех пор символом хирургии паращитовидных желез является носорог. У человека этот орган был выявлен позднее, в 1880 году, студентом медицинского университета г. Уппсала Иваром Сандстромом. Однако, только в 1925 году в Вене хирург Феликс Майндль сумел успешно удалить аденому паращитовидной железы у пациента с поражением костей и тем самым вылечить больного.
Заболевания паращитовидных желез
Наиболее частыми болезнями являются:
- первичный гиперпаратиреоз (связан с развитием аденомы – доброкачественной опухоли, которая может быть одиночной или множественной);
- вторичный гиперпаратиреоз (развивается при дефиците витамина D – эта форма лечится устранением дефицита путем приема соответствующих препаратов; другая форма вторичного гиперпаратиреоза развивается при хронической почечной недостаточности и лечится консервативно или хирургическим путем);
- третичный гиперпаратиреоз (развивается при длительно существующей хронической почечной недостаточности и корректируется только хирургически).
Операции на паращитовидных железах
Лечением болезней паращитовидных желез занимаются эндокринологи, а операции на этом органе проводят хирурги-эндокринологи, причем только имеющие достаточный опыт в данной области хирургии. Проведение операций хирургами, не имеющими достаточного опыта в области хирургии паращитовидных желез, в значительном проценте случаев приводит к сохранению заболевания, а также к ряду опасных осложнений.
В настоящее время российским лидером в области подобных операций является Северо-Западный центр эндокринологии, специалисты которого ежегодно выполняют более 300 вмешательств данного типа. В подавляющем большинстве случаев операции проводятся малотравматичным доступом с использованием видеотехники, что позволяет сократить длину кожного шва до 1,5-2,5 см, а время операции – до 10-20 минут. Безусловно, подобные результаты достигаются только при использовании современных принципов диагностики и такого же современного оборудования.
К сожалению, часто к хирургу-эндокринологу направляются для операции пациенты, которых хирургическое лечение вообще не требуется. Наиболее частой ошибкой является назначение операции пациентам с дефицитом витамина D, который приводит к повышению уровня паратгормона крови. В подобных случаях опытный хирург-эндокринолог рекомендует пациенту вместо операции начать прием препаратов кальция или витамина D и тем самым полностью устранить имеющуюся проблему.
Паратгормон
Всё о паратгормоне - что это такое, структура паратгормона и его действие, механизм выработки, взаимодействие с другими веществами (кальцием, кальцитонином, витамином Д), причины повышения и снижения паратгормона, информация где сдать парагормон
Синдром множественных эндокринных неоплазий I типа (синдром МЭН-1)
Синдром множественных эндокринных неоплазий 1 типа, именуемый иначе синдромом Вермера, представляет собой сочетание опухолей или гиперплазий в двух и более органах эндокринной системы (как правило, в опухолевый процесс вовлечены паращитовидные железы, наряду с которыми обнаруживаются островково-клеточные новообразования поджелудочной железы и аденома гипофиза)
Аденома паращитовидной железы (первичный гиперпаратиреоз, вторичный и третичный гиперпаратиреоз)
Аденома паращитовидной железы - информация о причинах возникновения, симптомах, методах диагностики и лечения
Если кальций в крови повышен.
Что делать, если кальций крови повышен? О каких заболеваниях может говорить повышенный кальций крови? Какие дополнительные обследования необходимо сделать пациентам с высоким кальцием? Куда обратиться для консультации по поводу повышенного содержания кальция в крови? На все эти вопросы отвечает данная статья
Псевдогипопаратиреоз
Псевдогипопаратиреоз или болезнь Олбрайта - редкое наследственное заболевание, характеризующееся поражением костной системы вследствие нарушения фосфорно-кальциевого метаболизма, возникающего из-за резистентности тканей к паратгормону, вырабатываемому паращитовидными железами
Анализы в СПб
Одним из важнейших этапов диагностического процесса является выполнение лабораторных анализов. Чаще всего пациентам приходится выполнять анализ крови и анализ мочи, однако нередко объектом лабораторного исследования являются и другие биологические материалы.
Консультация эндокринолога онлайн
Если вам необходимо получить консультацию эндокринолога, но возможности очно посетить специалиста нет, то оптимальным решением станет оформление дистанционной консультации.
Операции на паращитовидных железах
Северо-Западный центр эндокринологии и эндокринной хирургии проводит операции по удалению аденом паращитовидных желез при всех видах гиперпаратиреоза. Ежегодно нашими пациентами становятся более 800 пациентов с данным заболеванием
Консультация эндокринолога
Специалисты Северо-Западного центра эндокринологии проводят диагностику и лечение заболеваний органов эндокринной системы. Эндокринологи центра в своей работе базируются на рекомендациях Европейской ассоциации эндокринологов и Американской ассоциации клинических эндокринологов. Современные диагностические и лечебные технологии обеспечивают оптимальный результат лечения.
Экспертное УЗИ щитовидной железы
УЗИ щитовидной железы является главным методом, позволяющим оценить строение этого органа. Благодаря своему поверхностному расположению, щитовидная железа легко доступна для проведения УЗИ. Современные ультразвуковые аппараты позволяют осматривать все отделы щитовидной железы, за исключением расположенных за грудиной или трахеей.
Анализ на витамин Д
Анализ крови на Витамин Д покажет достаточное ли количество витамина Д получает организм человека. В зоне повышенного риска дефицита витамина Д находятся жители всей территории России.
УЗИ шеи
Информация об УЗИ шеи - входящие в него исследования, их особенности
Операции при вторичном и третичном гиперпаратиреозе
Информация для пациентов с хронической болезнью почек (хронической почечной недостаточностью), нуждающихся в оперативном лечении по поводу вторичного или третичного гиперпаратиреоза
Консультация хирурга-эндокринолога
Хирург-эндокринолог – врач, специализирующийся на лечении заболеваний органов эндокринной системы, требующих использования хирургических методик (оперативного лечения, малоинвазивных вмешательств)
Интраоперационный нейромониторинг
Интраоперационный нейромониторинг - методика контроля электрической активности гортанных нервов, обеспечивающих подвижность голосовых связок, во время операции. При проведении мониторинга хирург имеет возможность каждую секунду оценивать состояние гортанных нервов и соответственно менять план операции. Нейромониторнг позволяет резко снизить вероятность развития нарушения голоса после операций на щитовидной железе и околощитовидных железах.
Денситометрия
Денситометрия — метод определения плотности костной ткани человека. Термин «денситометрия» (от латинского densitas — плотность, metria — измерение) применяется к методам количественного определения плотности костной ткани или ее минеральной массы. Плотность костной ткани может определяться с помощью рентгеновской или ультразвуковой денситометрии. Данные, полученные в ходе денситометрии, обрабатываются с помощью компьютерной программы, которая сравнивает результаты с показателями, принятыми в качестве нормы для людей соответствующего пола и возраста. Плотность костной ткани является основным показателем, определяющим прочность кости, ее устойчивость к механической нагрузке
Диагностика и лечение гинекологических заболеваний, консультирование семейных пар по вопросам лечения бесплодия ЭндокринологДиагностика и лечение сахарного диабета, ожирения, остеопороза Хирург-эндокринологДиагностика и лечение заболеваний щитовидной железы, околощитовидных желез, надпочечников Диетолог-эндокринологЛечение ожирения, диагностика эндокринных причин ожирения, комплексные программы снижения веса Андролог Помощь в решении мужских проблем: бесплодия, нарушения потенции, воспалительных заболеваний Детский эндокринологДиагностика и лечение эндокринных заболеваний у детей до 18 лет МаммологДиагностика и лечение заболеваний молочных желез
Отзывы
Истории пациентов
Видеоотзывы: опыт обращения в Северо-Западный центр эндокринологии
Услуги
Экспертное УЗИ щитовидной железы
УЗИ щитовидной железы выполняется хирургами-эндокринологами с использованием аппаратов экспертного класса
Денситометрия: ультразвуковая
Денситометрия (определение плотности костной ткани) - без облучения, выполняется эндокринологом
Гормоны щитовидной железы
Всё о сдаче анализа на гормоны щитовидной железы: какие гормоны существуют, как сдавать гормоны, где сдавать анализ на гормоны
Удаление щитовидной железы
Информация об удалении щитовидной железы в Северо-Западном центре эндокринологии
Сотрудничество с центром
Возможности сотрудничества
Варианты и обсуждение вопросов сотрудничества с Северо-Западным центром эндокринологии
Специалисты Центра эндокринологии регулярно участвуют в международных конгрессах, стажировках, обучающих семинарах. За 3 года специалистами центра получено 15 патентов РФ на изобретения
Читайте также:
